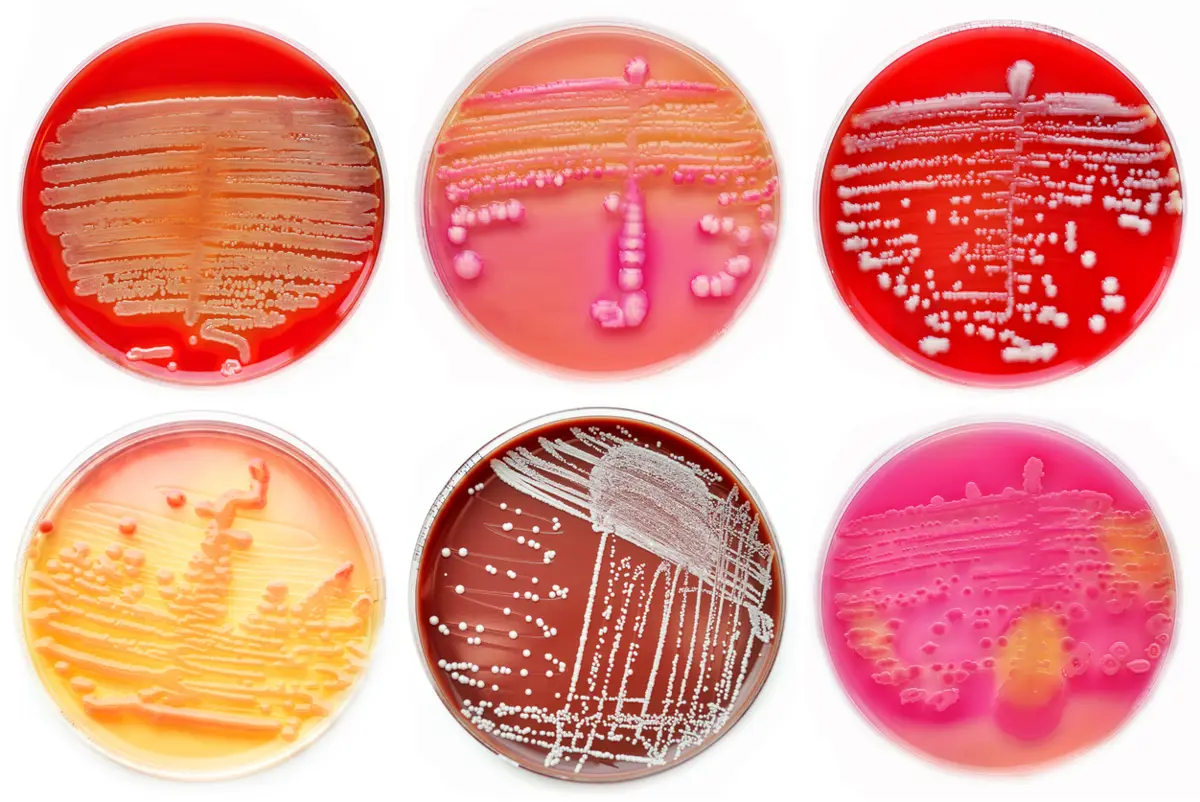

Uppsala Reports editor
@UMCGlobalSafety
Communications / 27 April 2021
Photo: iStock
Antimicrobial resistance threatens one of the key pillars of modern medicine. The latest episode of Drug Safety Matters asks how we got here – and how we get out.
Antimicrobial resistance (AMR) is not only a biological issue, but a complex social problem. As a consequence, changing the way patients, healthcare professionals and policymakers think about antibiotics will require input from both the natural and social sciences. In March 2021, the Uppsala Health Summit on “Managing antimicrobial resistance through behaviour change” tackled this very problem. We spoke to three key participants – Otto Cars, Eldar Shafir and Vanessa Carter – to learn more.
Otto Cars is founder and now senior advisor to ReACT (Action on Antibiotic Resistance). He set the scene at Uppsala Health Summit 2021 with a lecture on the current status of AMR globally. In a recent interview, he described how to make the most of the COVID-19 momentum to spur much-needed action in the AMR sphere.
Eldar Shafir is professor of behavioural science and public policy at Princeton University, with a special interest in the effect of poverty on decision-making. In his keynote lecture at the summit, he commented on the AMR problem from a behavioural perspective. He points us to a 2016 research paper on the effect of behavioural interventions on inappropriate antibiotic prescribing.
Vanessa Carter is a South Africa-based patient advocate for AMR and e-patient scholar at Stanford University Medicine X. She suggests reading Tom Ferguson’s white paper on e-patients and their contribution to healthcare.
This episode was produced in collaboration with The AMR Studio podcast at Uppsala Antibiotic Center. Tune into their show for more stories on antimicrobial resistance.

Subscribe by visiting the Drug Safety Matters website or listen in right here:
How can we make healthcare safer for children? ISoP’s Angela Caro-Rojas shares insights ahead of World Patient Safety Day.
04 September 2025
Oman’s VigiMobile launch is more than a technical upgrade. It signals a strong commitment to patient safety and public participation in pharmacovigilance.
17 September 2025
Prof. Singhal passed away on 19 April 2025. He is survived by his wife, children, and a large community of pharmacology researchers who had the privilege of training under him.
02 July 2025